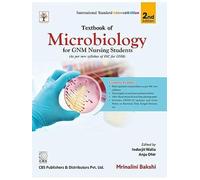
Textbook of Microbiology for GNM Nursing Students

Ananthanarayan And Panikers Textbook Of Microbiology
£19.20
Amazon-marketplace.co.uk
Delivery from £20.58

Textbook of Microbiology and Immunology - 3E - Paperback (2017)
£21.10
Amazon-marketplace.co.uk
Delivery from £2.99

Infectious Disease Principles Textbook: Microbiology, Diagnosis, and Antimicrobial Therapy for USMLE Step 1, Step 2, and Board Review
£187.49
amazon.co.uk
Free Delivery

GENERAL MICROBIOLOGY FOR PHARMACY: A Unit-I Based Textbook of BP303T Covering Fundamentals of Pharmaceutical Microbiology: 1
£8.15
amazon.co.uk
Delivery from £2.99

Koneman's Color Atlas and Textbook of Diagnostic Microbiology
£102.79
Amazon-marketplace.co.uk
Free Delivery

Textbook of Microbiology for Health Sciences
£30.99
amazon.co.uk
Free Delivery

FUNGI, VIRUSES, DISINFECTANTS & STERILITY TESTING in Pharmaceutical Microbiology: A Concept-Oriented and Practice Focused Textbook Covering ... (Fundamentals of Pharmaceutical Microbiology)
£8.17
amazon.co.uk
Delivery from £2.99


Textbook of Industrial Microbiology
£69.99
amazon.co.uk
Free Delivery



FUNGI, VIRUSES, DISINFECTANTS & STERILITY TESTING in Pharmaceutical Microbiology: A Concept-Oriented and Practice Focused Textbook Covering ... (Fundamentals of Pharmaceutical Microbiology)
£15.59
amazon.co.uk
Free Delivery

Textbook of Soil Microbiology
£15.00
Amazon-marketplace.co.uk
Delivery from £3.20

GENERAL MICROBIOLOGY FOR PHARMACY: A Unit-I Based Textbook of BP303T Covering Fundamentals of Pharmaceutical Microbiology
£15.56
amazon.co.uk
Free Delivery

Textbook of Environmental Microbiology
£15.35
Amazon-marketplace.co.uk
Free Delivery

PHARMACEUTICAL MICROBIOLOGY (Based on PCI Curriculum for Bachelor of Pharmacy): A Textbook for Undergraduate Pharmacy Students: As per PCI Syllabus
£15.59
amazon.co.uk
Free Delivery

Oxford Textbook of Medical Mycology: A Guide for Scientists and Clinicians (Oxford Textbooks in Infectious Disease and Microbiology)
£135.00
amazon.co.uk
Free Delivery

PHARMACEUTICAL MICROBIOLOGY (Based on PCI Curriculum for Bachelor of Pharmacy): A Textbook for Undergraduate Pharmacy Students: As per PCI Syllabus
£8.16
amazon.co.uk
Delivery from £2.99

Asm Bks.: Manual of Clinical Microbiology, 4 Volume Set by Michael A. Pfaller...
£248.50
ebay.co.uk
Free Delivery

Tietz Textbook of Laboratory Medicine
£247.94
Whsmith.co.uk
Free Delivery

Fermentation Microbiology and Biotechnology, Fourth Edition - 9780367656706
£49.43
ebay.co.uk
Free Delivery

A Textbook of Fungi, Bacteria and Viruses (3rd Edition)
£8.90
Amazon-marketplace.co.uk
Free Delivery


Textbook of General Virology
£56.99
Whsmith.co.uk
Free Delivery

Oral Microbiology
£47.49
Whsmith.co.uk
Free Delivery

Industrial Microbiology
£58.90
Whsmith.co.uk
Free Delivery

The Gut Microbiome in Health and Disease : A Textbook
£94.99
Whsmith.co.uk
Free Delivery

PCR for Clinical Microbiology : An Australian and International Perspective
£170.99
Whsmith.co.uk
Free Delivery

Medical Microbiology
£76.94
Whsmith.co.uk
Free Delivery

Hugo and Russell's Pharmaceutical Microbiology
£52.24
Whsmith.co.uk
Free Delivery

Microbiology, International Adaptation
£62.69
Whsmith.co.uk
Free Delivery

Food Microbiology : An Introduction
£98.80
Whsmith.co.uk
Free Delivery

Environmental Microbiology
£52.24
Whsmith.co.uk
Free Delivery

Food Microbiology
£42.74
Whsmith.co.uk
Free Delivery
🤖 Ask ChatGPT
🛍️ What are the most important purchase criteria?
💰 Tell me the best deals!
📋 Create a short summary!
Informations about "textbook of microbiology"
Compare 111 offers for your search.
Pricehunter was able to locate products in 5 categories, ranging from £8.15 to £367.00.
About "textbook of microbiology"
- In total, Pricehunter was able to locate 4 offers, from providers such as Amazon-marketplace.co.uk, amazon.co.uk, Whsmith.co.uk and ebay.co.uk.
- After having chosen your supplier you may also choose the delivery company. 5 delivery companies are available Oxford University Press, Springer Verlag, Elsevier and Saunders being the most popular.
- The most offers (7) were found in the price range from £15.00 to £15.99.
- Customers who looked for this item also found interesting.
- With our extensive colour palette you can select your favourite colour for your article. Of the available 0 shades is the most frequently chosen.
Don't forget your voucher code:
Report Illegal Concerns
You are about to report a violation based on the EU Digital Services Act (DSA).